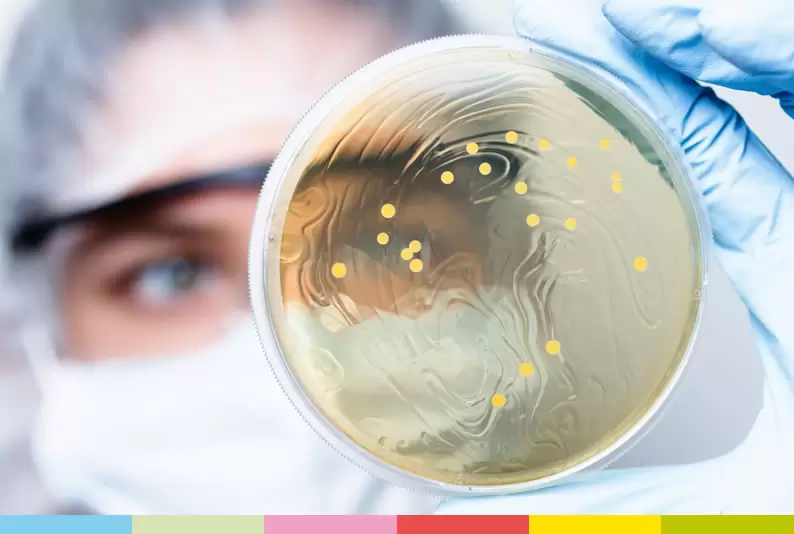

Laboratuvar Cihazları Ürünleri

Genel Laboratuvar Cihazları

Su Analizi Ölçüm Cihazları

Radrasyon Ölçüm Cihazları
Mikrobiyolojik Ölçüm Cihazları
Online Analizör Ürünleri

Atık Su Ölçüm Analizörleri

İçme Suyu Ölçüm Analizörleri

Yüzey Suları Ölçüm Analizörleri

Proses Suları Analizörleri

Havuz Suyu Ölçüm Analizörleri

Radrasyon İzleme Monitörleri
Portatif Ürünler

İçme Suyu Analiz Ürünleri

Havuz Suyu Analiz Ürünleri

Toprak Analiz Ürünleri

Proses Suyu Analiz Ürünleri

Radyasyon Dozimetre Analiz Ürünleri

Mobil Laboratuvarlar
